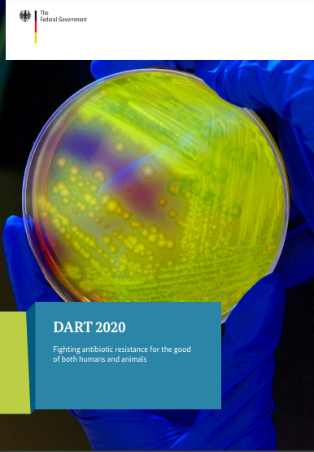

Germany: Fighting antibiotic resistance for the good of both humans and animals
2015-2020
1 January 2015
| Publication
WHO Team
National Action Plans and Monitoring and Evaluation (NPM)
Number of pages
32
